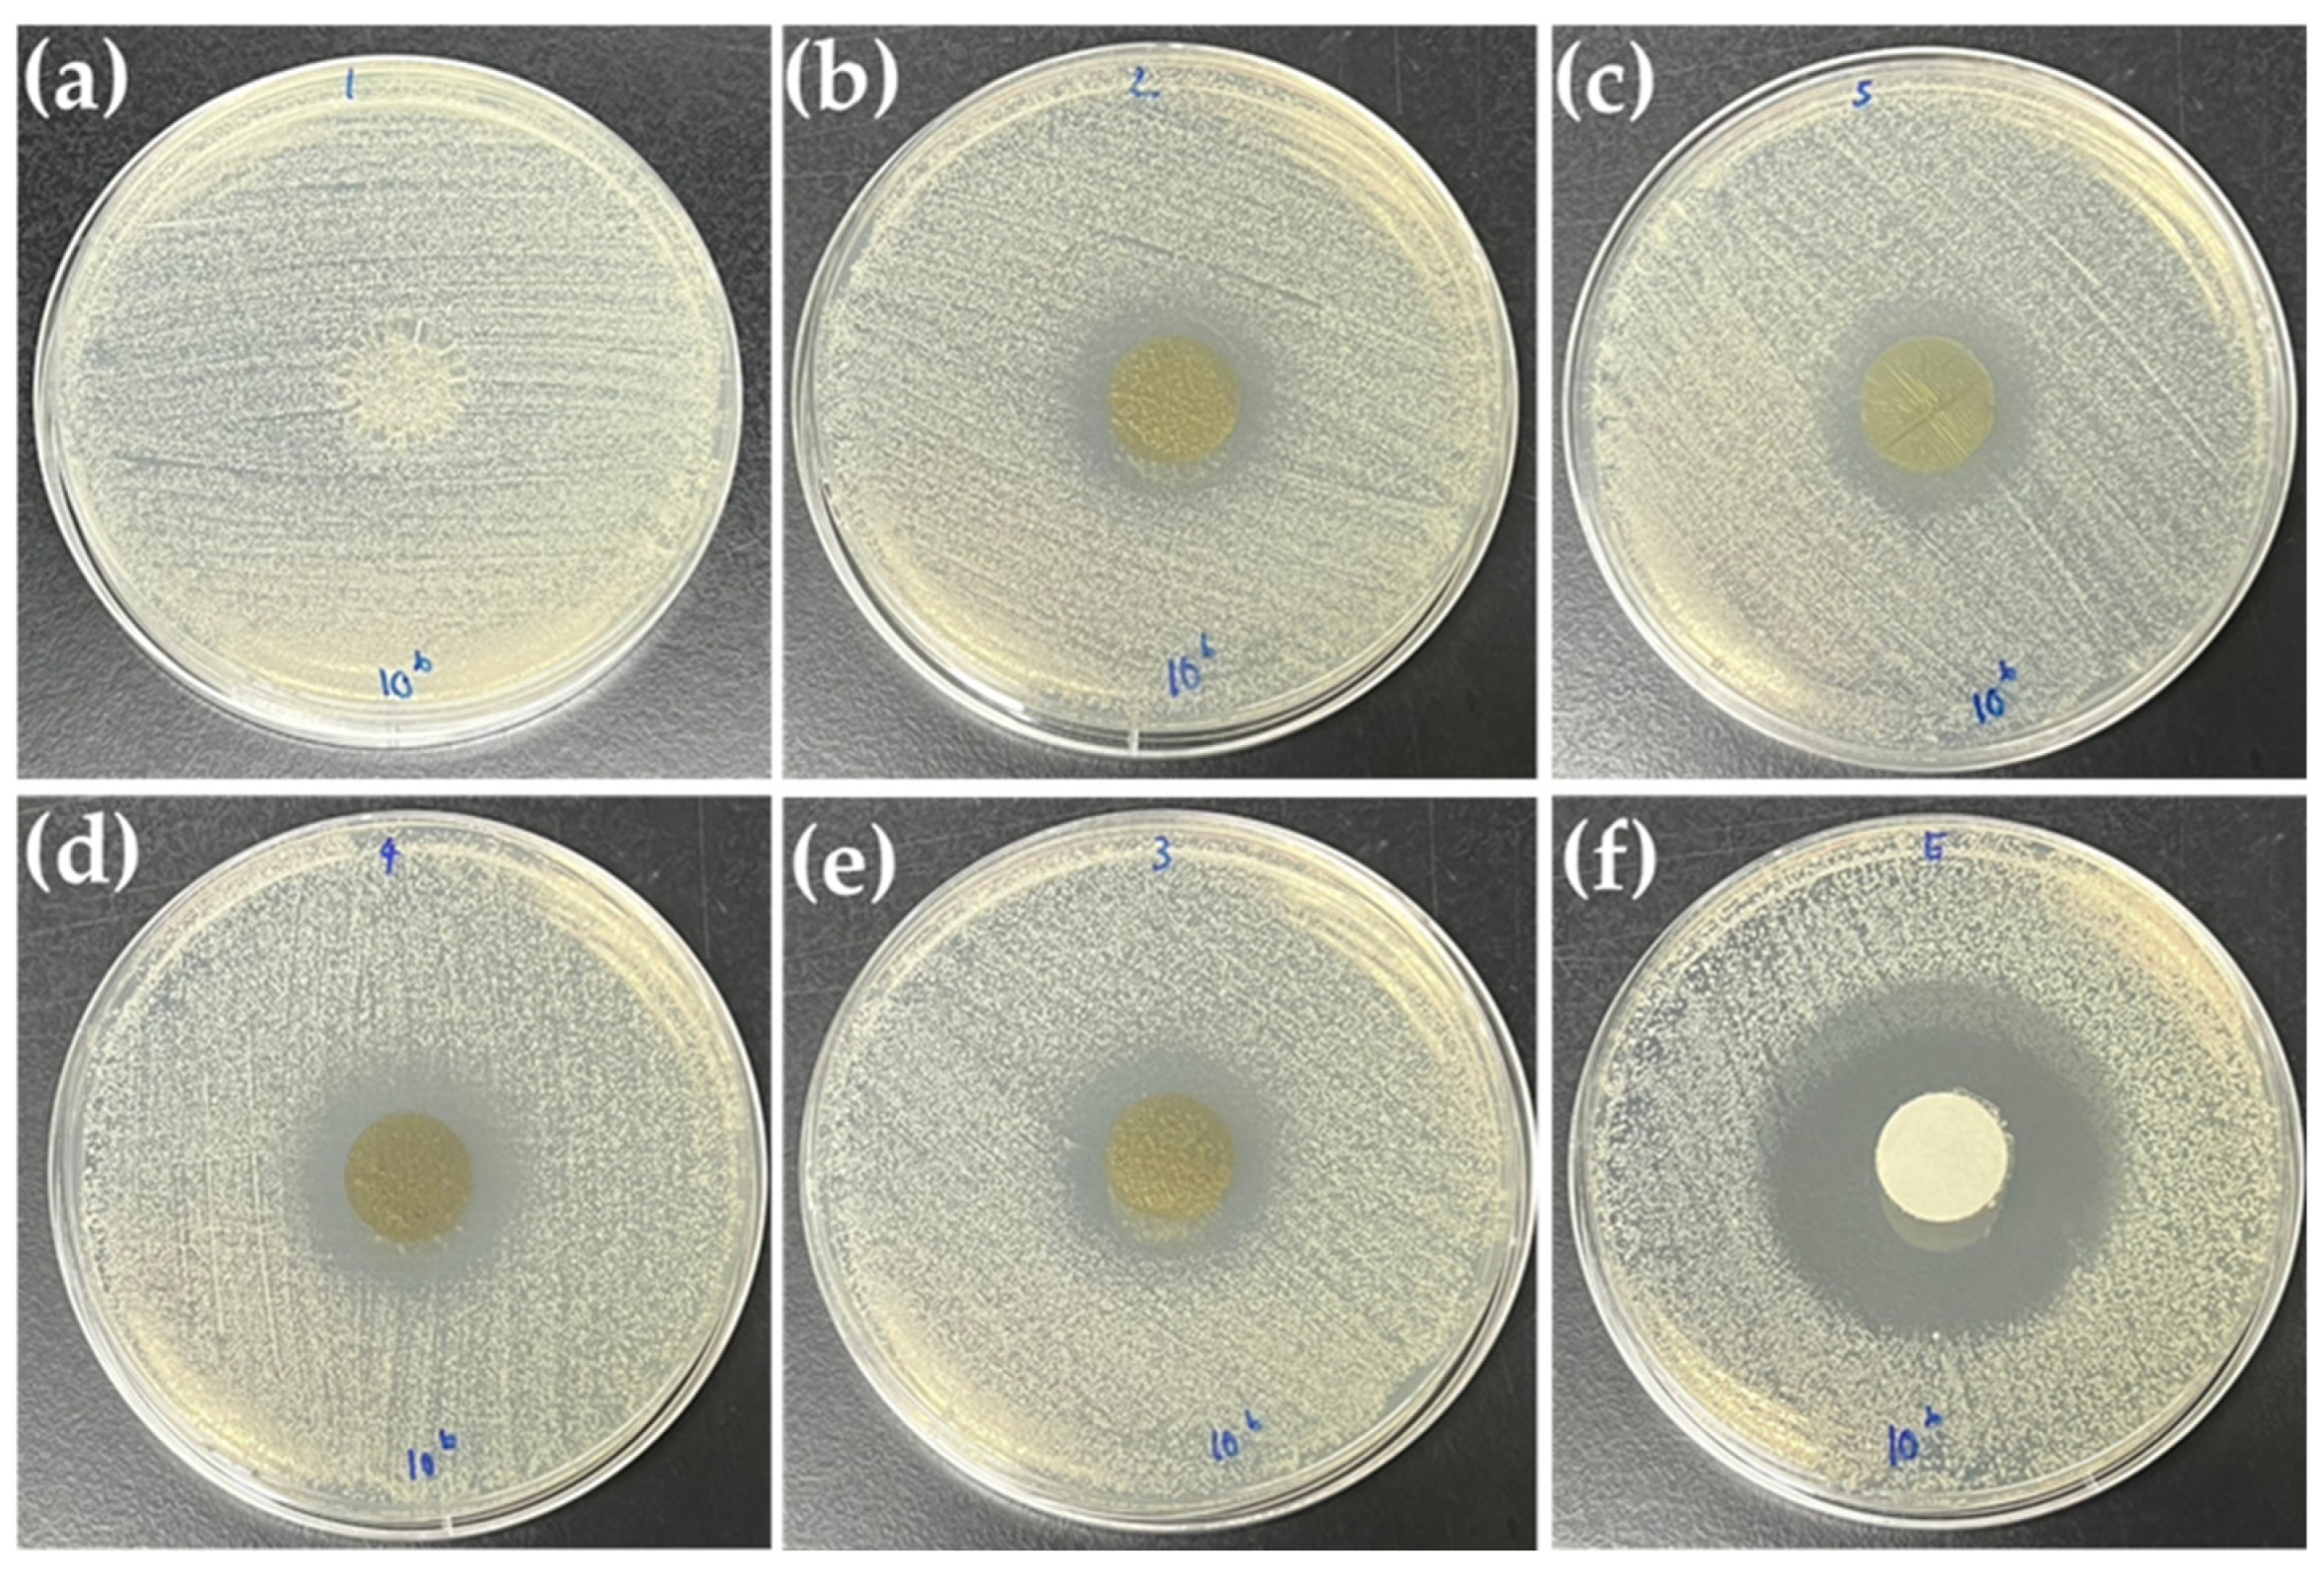
Foods 14 00804 g007

Development of Bioactive Edible Film and Coating Obtained from Spirogyra sp. Extract Applied for Enhancing Shelf Life of Fresh Products
Abstract
1. Introduction
2. Materials and Methods
2.1. Chemical
2.2. Preparation of Bioactive Crude Algae Extract
2.3. Bioactive Analysis
2.3.1. Total Phenolic Content (TPC) Determination
2.3.2. Antioxidant Activity Measurement
- 2,2-Diphenyl-1-picrylhydrazyl (DPPH) Radical Scavenging Activity
- Ferric Reducing Antioxidant Power (FRAP) Determination
- ABTS Radical Scavenging Activity
2.3.3. Chlorophyll Determination
2.4. Microbiological Analysis
2.5. Active Edible Films and Coatings Formation
2.6. Film Evaluation
2.6.1. Transparency of Active Edible Films
2.6.2. Fourier Transform Infrared (FTIR) Spectroscopy
2.6.3. Scanning Electron Microscopy (SEM) Analysis
2.6.4. Determination of Mechanical Properties
2.6.5. Water Vapor Permeability (WVP) Analysis
2.6.6. Antimicrobial Test of Bio-Composite Films
2.7. Shelf-Life Study of Okra (Abelmoschus esculentus)
Edible Coating Application
2.8. Coated Okra Characterization
2.8.1. Weight Loss Determination
2.8.2. Color Measurement
2.8.3. Firmness and Toughness
2.9. Cytotoxicity Study
2.10. Data Analysis
3. Results
3.1. Biochemical and Microbiological Analysis
3.2. Flim Characterization
3.2.1. FTIR Analysis
3.2.2. Film Surface Morphology
3.2.3. Water Vapor Permeability of Developed Films
3.2.4. Color Parameters
3.2.5. Transparency of Films
3.2.6. Antioxidant Activity and Total Phenolic Content
3.2.7. Antimicrobial Result of Bio-Composite Films
3.2.8. Mechanical Properties
3.3. Biocompatibility of the Formulated Active Coating Solution
3.4. Shelf-Life of Coated- Okra (Abelmoschus esculentus)
3.4.1. Weight Loss
3.4.2. Firmness and Toughness Analysis
3.4.3. Color of Coated Okra
4. Conclusions
Author Contributions
Funding
Institutional Review Board Statement
Informed Consent Statement
Data Availability Statement
Acknowledgments
Conflicts of Interest
References
- Das, D.; Panesar, P.S.; Saini, C.S.; Kennedy, J.F. Improvement in Properties of Edible Film Through Non-Thermal Treatments and Nanocomposite Materials: A Review. Food Pack. Shelf. 2022, 32, 100843. [Google Scholar] [CrossRef]
- Davoodi, S.; Davachi, S.M.; Ghorbani Golkhajeh, A.; Shekarabi, A.S.; Abbaspourrad, A. Development and Characterization of Salvia macrosiphon/Chitosan Edible Films. ACS Sustain. Chem. Eng. 2020, 8, 1487–1496. [Google Scholar] [CrossRef]
- Kumar, N.; Pratibha; Trajkovska Petkoska, A.; Khojah, E.; Sami, R.; Al-Mushhin, A.A.M. Chitosan Edible Films Enhanced with Pomegranate Peel Extract: Study on Physical, Biological, Thermal, and Barrier Properties. Materials 2021, 14, 3305. [Google Scholar] [CrossRef] [PubMed]
- Karkar, B.; Patır, İ.; Eyüboğlu, S.; Şahin, S. Development of an Edible Active Chitosan Film Loaded with Nigella sativa L. Extract to Extend the Shelf life of Grapes. Biocatal. Agric. Biotechnol. 2023, 50, 102708. [Google Scholar] [CrossRef]
- Deshmukh, R.K.; Gaikwad, K.K. Natural Antimicrobial and Antioxidant Compounds for Active Food Packaging Applications. Biomass Conv. Bioref. 2024, 14, 4419–4440. [Google Scholar] [CrossRef]
- Cao, W.; Yan, J.; Liu, C.; Zhang, J.; Wang, H.; Gao, X.; Yan, H.; Niu, B.; Li, W. Preparation and Characterization of Catechol-grafted Chitosan/gelatin/modified chitosan-AgNP Blend Films. Carbohydr. Polym. 2020, 247, 116643. [Google Scholar] [CrossRef]
- Elsabee, M.Z.; Abdou, E.S. Chitosan Based Edible Films and Coatings: A review. Mater. Sci. Eng. C 2013, 33, 1819–1841. [Google Scholar] [CrossRef] [PubMed]
- Nxumalo, K.A.; Fawole, O.A.; Aremu, A.O. Development of Chitosan-Based Active Films with Medicinal Plant Extracts for Potential Food Packaging Applications. Processes 2024, 12, 23. [Google Scholar] [CrossRef]
- Carina, D.; Sharma, S.; Jaiswal, A.K.; Jaiswal, S. Seaweeds Polysaccharides in Active Food Packaging: A Review of Recent Progress. Trends Food Sci. 2021, 110, 559–572. [Google Scholar] [CrossRef]
- Mohan, A.A.; Antony, A.R.; Greeshma, K.; Yun, J.-H.; Ramanan, R.; Kim, H.-S. Algal Biopolymers as Sustainable Resources for a Net-zero Carbon Bioeconomy. Bioresour. Technol. 2022, 344, 126397. [Google Scholar] [CrossRef]
- Kajla, P.; Chaudhary, V.; Dewan, A.; Bangar, S.P.; Ramniwas, S.; Rustagi, S.; Pan-diselvam, R. Seaweed-based Biopolymers for Food Packaging: A Sustainable Approach for a Cleaner Tomorrow. Int. J. Biol. Macromol. 2024, 274, 133166. [Google Scholar] [CrossRef] [PubMed]
- Wu, J.Y.; Tso, R.; Teo, H.S.; Haldar, S. The Utility of Algae as Sources of High Value Nutritional Ingredients, Particularly for Alternative/Complementary Proteins to Improve Human Health. Front. Nutr. 2023, 10, 1277343. [Google Scholar] [CrossRef] [PubMed]
- Kumar, L.; Ramakanth, D.; Akhila, K.; Gaikwad, K.K. Edible Films and Coatings for Food Packaging Applications: A Review. Environ. Chem. Lett. 2022, 20, 875–900. [Google Scholar] [CrossRef]
- Yosboonruang, A.; DuangjaI, A.; Amormlerdpison, D.; Viyoach, J. Screening for Biological Activities of Spirogyra neglecta Water Extract. Walailak J. Sci. Technol. 2018, 17, 359–368. [Google Scholar] [CrossRef]
- Belyagoubi, L.; Belyagoubi-Benhammou, N.; Atik-Bekkara, F.; Abdelouahid, D.E. Influence of Harvest Season and Different Polarity Solvents on Biological activities, Phenolic Compounds and Lipid-soluble Pigment Contents of Spirogyra sp. from Algeria. Adv. Tradit. Med. 2022, 22, 359–369. [Google Scholar] [CrossRef]
- Wang, H.; Cao, Z.; Yao, L.; Feng, T.; Song, S.; Sun, M. Insights into the Edible and Biodegradable Ulvan-Based Films and Coatings for Food Packaging. Foods 2023, 12, 1622. [Google Scholar] [CrossRef]
- Waseem, M.; Khan, M.U.; Majeed, Y.; Ntsefong, G.N.; Kirichenko, I.; Klopova, A.; Trushov, P.; Lodygin, A. Seaweed-based Films for Sustainable Food Packaging: Properties, Incorporation of Essential Oils, Applications, and Future Directions. Potravin. Slovak J. Food Sci. 2023, 17, 899–917. [Google Scholar] [CrossRef]
- Liu, X.; Xu, Y.; Zhan, X.; Xie, W.; Yang, X.; Cui, S.W.; Xia, W. Development and Properties of New Kojic Acid and Chitosan Composite Biodegradable Films for Active Packaging Materials. Int. J. Biol. Macromol. 2020, 144, 483–490. [Google Scholar] [CrossRef] [PubMed]
- Joshi, P.; Becerra-Mora, N.; Vargas-Lizarazo, A.Y.; Kohli, P.; Fisher, D.J.; Choudhary, R. Use of Edible Alginate and Limonene Liposome Coatings for Shelf-life Improvement of Blackberries. Future Foods 2021, 4, 100091. [Google Scholar] [CrossRef]
- Xue, F.; Zhao, M.; Liu, X.; Chu, R.; Qiao, Z.; Li, C.; Adhikari, B. Physicochemical Properties of Chitosan/Zein/Essential oil Emulsion-based Active Films Functionalized by Polyphenols. Future Foods 2021, 3, 100033. [Google Scholar] [CrossRef]
- Gomaa, M.; Hifney, A.F.; Fawzy, M.A.; Abdel-Gawad, K.M. Use of Seaweed and Filamentous Fungus Derived Polysaccharides in the Development of Alginate-Chitosan Edible Films Containing Fucoidan: Study of Moisture Sorption, Polyphenol Release and Antioxidant Properties. Food Hydrocoll. 2018, 82, 239–247. [Google Scholar] [CrossRef]
- Zaghbib, I.; Abdullah, J.A.A.; Romero, A. Development of a Multifunctional Chitosan-Based Composite Film from Crab Shell (Portunus segnis) and Algae (Ulva lactuca) with Enhanced Antioxidant and Antimicrobial Properties for Active Food Packaging. Foods 2025, 14, 53. [Google Scholar] [CrossRef]
- Ceymann, M.; Arrigoni, E.; Schärer, H.; Bozzi Nising, A.; Hurrell, R.F. Identification of Apples Rich in Health-promoting flavan-3-ols and Phenolic acids by Measuring the Polyphenol Profile. J. Food Compos. Anal. 2012, 26, 128–135. [Google Scholar] [CrossRef]
- Vieira, F.G.K.; Borges, G.D.S.C.; Copetti, C.; Di Pietro, P.F.; Nunes, E.d.C.; Fett, R. Phenolic Compounds and Antioxidant Activity of the Apple Flesh and Peel of Eleven Cultivars Grown in Brazil. Sci. Hortic. 2011, 128, 261–266. [Google Scholar] [CrossRef]
- Benzie, I.F.F.; Strain, J.J. The Ferric Reducing Ability of Plasma (FRAP) as a Measure of “Antioxidant power”: The FRAP assay. Anal. Biochem. 1996, 239, 70–76. [Google Scholar] [CrossRef] [PubMed]
- Márquez-Reyes, J.M.; Rodríguez-Quiroz, R.E.; Hernández-Rodríguez, J.P.; Rodríguez-Romero, B.A.; Flores-Breceda, H.; Napoles-Armenta, J.; Romero-Soto, I.C.; Galindo-Rodríguez, S.A.; Báez-González, J.G.; Treviño-Garza, M.Z. Production and Characterization of Biocomposite Films of Bacterial Cellulose from Kombucha and Coated with Chitosan. Polymers 2022, 14, 3632. [Google Scholar] [CrossRef]
- Godlewska, K.; Michalak, I.; Tuhy, Ł.; Chojnacka, K. The Influence of pH of Extracting Water on The Composition of Seaweed Extracts and Their Beneficial Properties on Lepidium sativum. BioMed. Res. Int. 2017, 2017, 7248634. [Google Scholar] [CrossRef] [PubMed]
- Basri, D.F.; Fan, S.H. The Potential of Aqueous and Acetone Extracts of Galls of Quercus infectoria as Antibacterial Agents. Indian J. Pharmacol. 2005, 37, 26–29. [Google Scholar] [CrossRef]
- Qin, Y.Y.; Zhang, Z.H.; Li, L.; Yuan, M.L.; Fan, J.; Zhao, T.R. Physio-mechanical Properties of an Active Chitosan Film Incorporated with Montmorillonite and Natural Antioxidants Extracted from Pomegranate rind. J. Food Sci. Technol. 2015, 52, 1471–1479. [Google Scholar] [CrossRef] [PubMed]
- ASTM E96-00e1; Standard Test Methods for Water Vapor Transmission of Material. ASTM International: West Conshohocken, PA, USA, 1995.
- Chana-Thaworn, J.; Chanthachum, S.; Wittaya, T. Properties and Antimicrobial Activity of Edible Films Incorporated with kiam wood (Cotyleobium lanceotatum) extract. LWT—Food Sci. Technol. 2011, 44, 284–292. [Google Scholar] [CrossRef]
- Borges, M.M.; Simões, A.S.; Miranda, C.; Sales, H.; Pontes, R.; Nunes, J. Microbiological Assessment of White Button Mushrooms with an Edible Film Coating. Foods 2023, 12, 3061. [Google Scholar] [CrossRef] [PubMed]
- Mosmann, T. Rapid Colorimetric Assay for Cellular Growth and Survival: Application to Proliferation and Cytotoxicity assays. J. Immunol. Methods. 1983, 65, 55–63. [Google Scholar] [CrossRef] [PubMed]
- Assawarachan, R.; Nookong, M.; Chailungka, N.; Amornlerdpison, D. Effects of Microwave Power on the Drying Characteristics, Color and Phenolic Content of Spirogyra sp. J. Food Agric. Environ. 2013, 11, 15–18. [Google Scholar]
- Yarnpakdee, S.; Benjakul, S.; Senphan, T. Antioxidant Activity of the Extracts from Freshwater macroalgae (Cladophora glomerata) Grown in Northern Thailand and its Preventive Effect Against Lipid Oxidation of Refrigerated Eastern Little Tuna Slice. Turk. J. Fish. Aquat. Sci. 2019, 19, 209–219. [Google Scholar] [CrossRef] [PubMed]
- Junthip, R.; Amornlerdpison, D.; Chimsook, T. Phytochemical Screening, Antioxidant Activity and Total Phenolic Content of Spirogyra spp. Adv. Mater. Res. 2013, 699, 693–697. [Google Scholar] [CrossRef]
- Tipnee, S.; Ramaraj, R.; Unpaprom, Y. Nutritional Evaluation of Edible Freshwater Green Macroalga Spirogyra varians. Emer. Life Sci. Res. 2015, 1, 1–7. [Google Scholar]
- Thomas, N.V.; Ghafour, D.D.; Diyya, A.S.M.; Ismail, R.R.; Jalal, L.K. Antibacterial Effects of the Organic Crude Extracts of Freshwater Algae of Sulaymaniyah, Kurdistan Region, Iraq. J. Med. Plant Res. 2021, 15, 178–187. [Google Scholar] [CrossRef]
- Mohammed, D.H.; Al-Katib, M.A. Active and Phenolic Compounds in Spirogyra sp. PDNA1 is an Antibiotic for Some Bacteria and Fungi. Al-Kitab J. Pure Sci. 2023, 7, 100–113. [Google Scholar] [CrossRef]
- Guleria, S.; Chawla, P.; Relhan, A.; Kumar, A.; Bhasin, A.; Zhou, J.L. Antibacterial and Photocatalytic Potential of Bioactive Compounds Extracted from Freshwater Microalgae species (Spirogyra and Ocillatoria): A comparative Analysis. Sci. Total Environ. 2024, 912, 169224. [Google Scholar] [CrossRef]
- Liu, Y.; Qin, Y.; Bai, R.; Zhang, X.; Yuan, L.; Liu, J. Preparation of pH-sensitive and Antioxidant Packaging Films Based on Kappa-carrageenan and Mulberry Polyphenolic Extract. Int. J. Biol. Macromol. 2019, 134, 993–1001. [Google Scholar] [CrossRef]
- Liu, Y.; Zhang, X.; Li, C.; Qin, Y.; Xiao, L.; Liu, J. Comparison of the Structural, Physical and Functional Properties of Kappa-carrageenan Films Incorporated with Pomegranate Flesh and Peel Extracts. Int. J. Biol. Macromol. 2020, 147, 1076–1088. [Google Scholar] [CrossRef] [PubMed]
- Han, H.-S.; Song, K.B. Noni (Morinda citrifolia) Fruit Polysaccharide Films Containing Blueberry (Vaccinium corymbosum) Leaf Extract as an Antioxidant Packaging Material. Food Hydrocoll. 2021, 112, 106372. [Google Scholar] [CrossRef]
- Albuquerque, P.B.S.; Cerqueira, M.A.; Vicente, A.A.; Teixeira, J.A.; Carneiro-da-Cunha, M.G. Immobilization of Bioactive Compounds in Cassia grandis Galactomannan-based Films: Influence on Physicochemical Properties. Int. J. Biol. Macromol. 2017, 96, 727–735. [Google Scholar] [CrossRef] [PubMed]
- Gontard, N.; Guilbert, S.; Cuq, J.L. Edible Wheat Gluten Films: Influence of the Main Process Variables on Film Properties Using Response Surface Methodology. J. Food Sci. 1992, 57, 190–195. [Google Scholar] [CrossRef]
- Martins, V.F.R.; Poças, F.; Pintado, M.; Morais, R.M.S.C.; Morais, A.M.M.B. Edible Films with Protein and Bioactive Compounds from Arthrospira sp. Biol. Life Sci. Forum. 2024, 40, 6. [Google Scholar] [CrossRef]
- Moradi, M.; Tajik, H.; Razavi Rohani, S.M.; Oromiehie, A.R.; Malekinejad, H.; Aliakbarlu, J.; Hadian, M. Characterization of Antioxidant Chitosan Film Incorporated with Zataria multiflora Boiss Essential oil and Grape Seed Extract. LWT—Food Sci. Technol. 2012, 46, 477–484. [Google Scholar] [CrossRef]
- Wilson, D.W.; Nash, P.; Buttar, H.S.; Griffiths, K.; Singh, R.; De Meester, F.; Horiuchi, R.; Takahashi, T. The Role of Food Antioxidants, Benefits of Functional Foods, and Influence of Feeding Habits on the Health of the Older Person: An Overview. Antioxidants 2017, 6, 81. [Google Scholar] [CrossRef]
- Wang, L.; Dong, Y.; Men, H.; Tong, J.; Zhou, J. Preparation and Characterization of Active Films based on chitosan Incorporated Tea Polyphenols. Food Hydrocoll. 2013, 32, 35–41. [Google Scholar] [CrossRef]
- Krishna, M.; Nindo, C.I.; Min, S.C. Development of Fish Gelatin Edible Films Using Extrusion and Compression Molding. J. Food Eng. 2012, 108, 337–344. [Google Scholar] [CrossRef]
- Liu, S.; Qiao, S.; Zhu, J.; Yang, Y.; Chen, H.; Dai, H.; Zhu, H.; Yu, Y.; Ma, L.; Zhang, Y.; et al. Enhanced Barrier and Antioxidant Properties of Gelatin Films by Structural-colored Bioactive Materials for Food Packaging. Food Hydrocoll. 2024, 150, 109744. [Google Scholar] [CrossRef]
- Biratu, G.; Woldemariam, H.W.; Gonfa, G. Development of Active Edible Films from Coffee Pulp Pectin, Propolis, and Honey with Improved Mechanical, Functional, Antioxidant, and Antimicrobial Properties. Carbohydr. Polym. 2024, 8, 100557. [Google Scholar] [CrossRef]
- 10993-5:2009; Biological Evaluation of Medical Devices—Part 5: Tests for In Vitro Cytotoxicity, 3rd ed. International Organization for Standardization: Geneva, Switzerland, 2009.
- Shinde, M.M.; Malik, M.; Kaur, K.; Gahlawat, V.K.; Kumar, N.; Chiraang, P.; Upadhyay, A. Formulization and Characterization of Guar Gum and Almond Gum Based Composite Coating and their Application for Shelf-life Extension of okra (Hibiscus esculentus). Int. J. Biol. Macromol. 2024, 262, 129630. [Google Scholar] [CrossRef] [PubMed]
- Gundewadi, G.; Rudra, S.G.; Sarkar, D.J.; Singh, D. Nanoemulsion Based Alginate Organic Coating for Shelf- Life Extension of Okra. Food Packag. Shelf Life. 2018, 18, 1–12. [Google Scholar] [CrossRef]

| Parameter | CBAE Result |
|---|---|
| Total phenolic content (mg GAE/g) | 1.10 ± 0.31 |
| DPPH antioxidant activity (mg GAE/g) | 2.15 ± 0.09 |
| FRAP antioxidant activity (mg GAE/g) | 14.59 ± 1.61 |
| ABTS antioxidant activity (mg GAE/g) | 0.28 ± 0.07 |
| Total Chlorophyll (mg/100 g) | 61.64 ± 0.02 |
| Sample | Firmness (N) | Sample | Toughness (N.s) | ||||
|---|---|---|---|---|---|---|---|
| Day1 | Day3 | Day5 | Day1 | Day3 | Day5 | ||
| Uncoated | 5.1 ± 1.5bAB | 6.3 ± 1.4 bAB | 10.5 ± 1.0 aAB | Uncoated | 21.6 ± 1.6 cA | 27.0 ± 1.9 bA | 46.9 ± 1.6 aA |
| CBAE0 | 9.3 ± 1.9 bA | 7.8 ± 1.6 bA | 10.9 ± 1.18 aA | CBAE0 | 28.6 ± 1.8 cA | 36.9 ± 2.2 bA | 35.7 ± 1.8 aA |
| CBAE5 | 7.3 ± 0.2 bAB | 7.7 ± 1.3 bAB | 9.1 ± 0.39 aAB | CBAE5 | 23.0 ± 0.9 cA | 30.8 ± 1.7 bA | 39.7 ± 1.8 aA |
| CBAE10 | 6.7 ± 0.5 bAB | 9.5 ± 1.1 bAB | 10.0 ± 1.6 aAB | CBAE10 | 24.0 ± 1.2 cA | 38.3 ± 1.5 bA | 35.5 ± 1.5 aA |
| CBAE15 | 7.2 ± 1.1 bAB | 7.0 ± 0.2 bAB | 10.2 ± 1.9 aAB | CBAE15 | 25.1 ± 1.4 cA | 33.3 ± 1.0 bA | 38.4 ± 1.2 aA |
| CBAE20 | 7.0 ± 0.2 bAB | 8.7 ± 1.9 bAB | 9.5 ± 1.8 aAB | CBAE20 | 22.6 ± 0.6 cA | 30.1 ± 1.8 bA | 39.5 ± 2.1 aA |
| CBAE25 | 6.7 ± 0.3 bAB | 7.6 ± 1.8 bAB | 9.2 ± 0.7 aAB | CBAE25 | 22.6 ± 2.1 cA | 28.6 ± 2.1 bA | 37.2 ± 1.0 aA |
| CBAE30 | 7.4 ± 1.3 bB | 7.0 ± 1.8 bB | 8.2 ± 0.6 aB | CBAE30 | 21.9 ± 1.5 cA | 32.9 ± 2.3 bA | 34.8 ± 1.2 aA |
Disclaimer/Publisher’s Note: The statements, opinions and data contained in all publications are solely those of the individual author(s) and contributor(s) and not of MDPI and/or the editor(s). MDPI and/or the editor(s) disclaim responsibility for any injury to people or property resulting from any ideas, methods, instructions or products referred to in the content. |
© 2025 by the authors. Licensee MDPI, Basel, Switzerland. This article is an open access article distributed under the terms and conditions of the Creative Commons Attribution (CC BY) license (https://creativecommons.org/licenses/by/4.0/).
Share and Cite
Soiklom, S.; Siri-anusornsak, W.; Petchpoung, K.; Soiklom, S.; Maneeboon, T. Development of Bioactive Edible Film and Coating Obtained from Spirogyra sp. Extract Applied for Enhancing Shelf Life of Fresh Products. Foods 2025, 14, 804. https://doi.org/10.3390/foods14050804
Soiklom S, Siri-anusornsak W, Petchpoung K, Soiklom S, Maneeboon T. Development of Bioactive Edible Film and Coating Obtained from Spirogyra sp. Extract Applied for Enhancing Shelf Life of Fresh Products. Foods. 2025; 14(5):804. https://doi.org/10.3390/foods14050804
Chicago/Turabian StyleSoiklom, Siriwan, Wipada Siri-anusornsak, Krittaya Petchpoung, Sumpan Soiklom, and Thanapoom Maneeboon. 2025. "Development of Bioactive Edible Film and Coating Obtained from Spirogyra sp. Extract Applied for Enhancing Shelf Life of Fresh Products" Foods 14, no. 5: 804. https://doi.org/10.3390/foods14050804
APA StyleSoiklom, S., Siri-anusornsak, W., Petchpoung, K., Soiklom, S., & Maneeboon, T. (2025). Development of Bioactive Edible Film and Coating Obtained from Spirogyra sp. Extract Applied for Enhancing Shelf Life of Fresh Products. Foods, 14(5), 804. https://doi.org/10.3390/foods14050804

